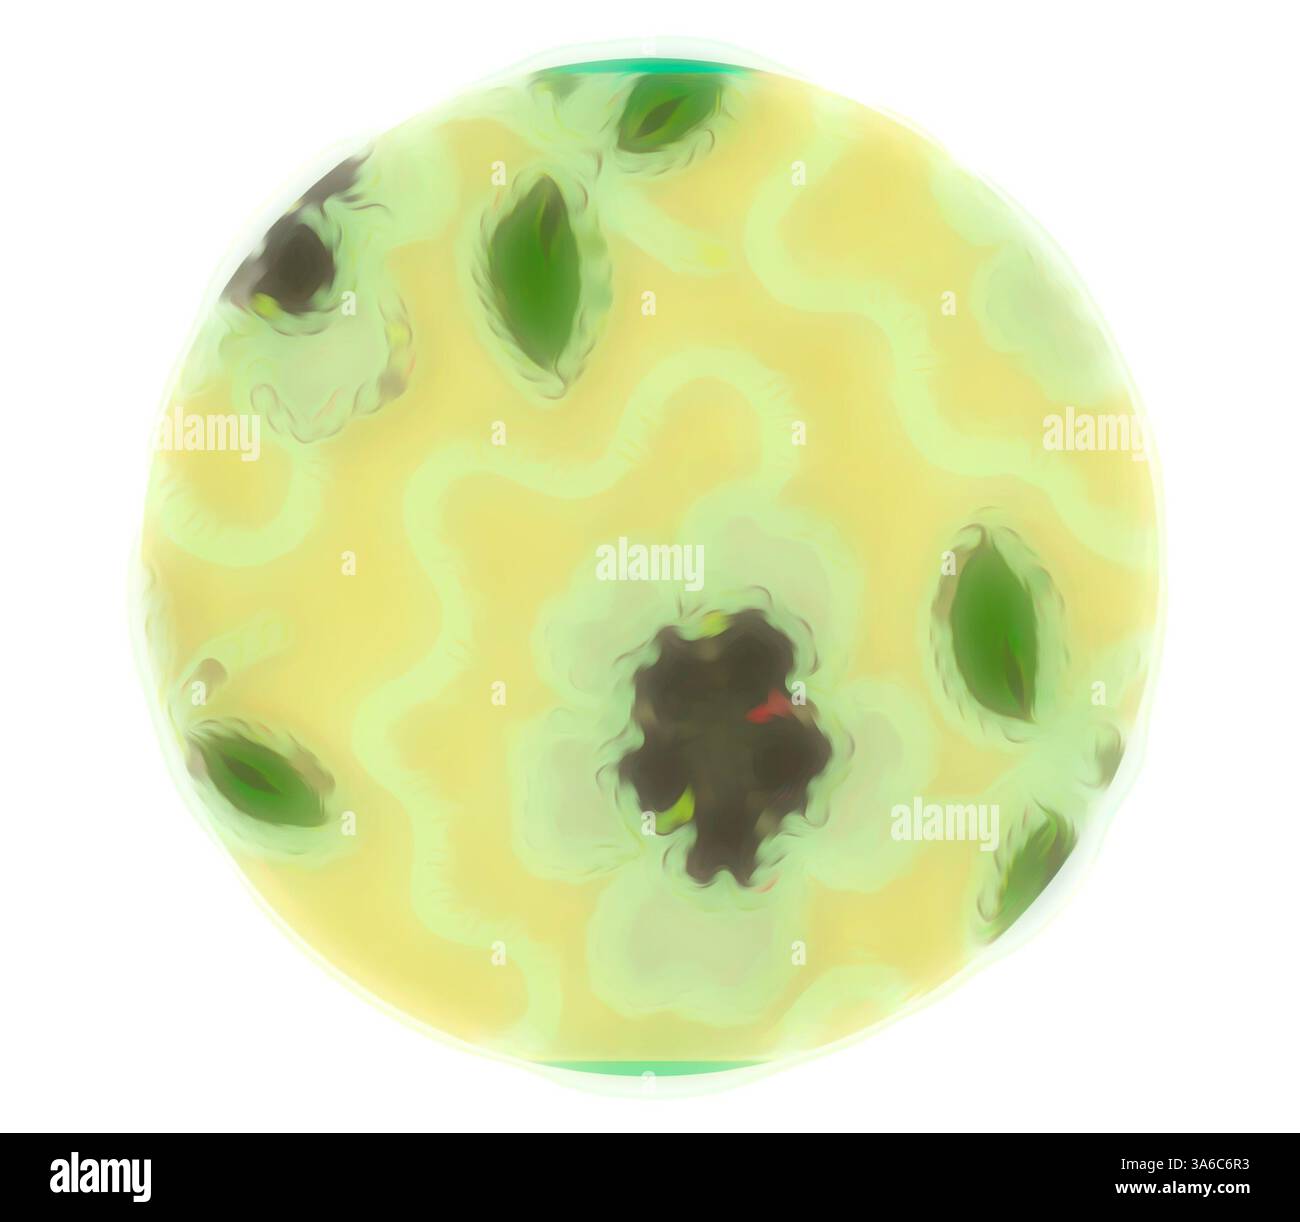
Une composition circulaire et abstraite avec des motifs doux et tourbillonnants et des teintes discrètes, évoquant un sens des formes organiques et des motifs inspirés de la nature. Les feuilles vertes délicates et les centres sombres suggèrent un thème floral ou botanique, créant une expérience visuelle tranquille et harmonieuse. Art classique avec une touche moderne réinventé par Artotop, transformé les tissus français, première moitié du XIXe siècle Banque D'Images

Floral theme Photos Stock & Des Images
(41)Floral theme Photos Stock & Des Images

RF3AYK205–Un design orné avec des chérubins, des motifs floraux et une draperie décorative, le tout encadré par une structure architecturale élaborée. Les détails complexes et la composition élégante suggèrent un thème classique, mettant l'accent sur l'art et la grandeur. Planche un, tiré d'Un nouveau livre d'ornements, 1704, Simon Gribelin II, français, 1661-1733, France, gravure sur papier ivoire, 196 × 161 mm (image/plaque), 195 × 233 mm (feuille) Art classique avec une touche moderne réinventée par Artotop

RF3AYYAFG–Un arrangement floral orné est élégamment exposé, entrelacé de rubans décoratifs. La conception commémore l'arrivée du duc et de la duchesse d'Édimbourg le 7 mars 1874, mettant en valeur des détails complexes et un thème historique. Arrivée du duc et de la duchesse d'Édimbourg 1874 Art classique avec une touche moderne réinventée par Artotop

RF3AYMNAW–Un personnage gracieux habillé d'un kimono traditionnel, orné de motifs floraux complexes, tient un objet circulaire tout en se tenant debout dans un cadre intérieur serein. Une calligraphie élégante accompagne la scène, évoquant un thème culturel ou poétique. L'acteur Hanagawa Ichinojo dans le rôle d'Akane Gozen dans la pièce Okunizome Shusse Butai, jouée au théâtre Ichimura au onzième mois, 1759, 1759, Torii Kiyomitsu I, japonais, 1735–1785, Japon, impression sur bois couleur, hosoban, benizuri-e, 12 1/2 x 5 3/4 po Art classique avec une touche moderne réinventé par Artotop

RM3A6DCFK–Une surface texturée avec un fond sombre orné de fleurs de tulipe rouge vif et de feuilles vertes délicates. Le design met en valeur un thème naturel et floral avec un élégant mélange de couleurs et de formes. Art classique avec une touche moderne réinventé par Artotop, transformé les tissus français, première moitié du XIXe siècle

RF3B0DF3D–Un affichage vibrant et abstrait de tons rouges et foncés, suggérant une sensation de profondeur et de mouvement à travers des formes douces et floues qui évoquent un thème floral., Un arrangement circulaire de feuilles rouges tourbillonnantes crée un motif vibrant et abstrait, évoquant une sensation de mouvement et de profondeur. Art classique avec une touche moderne réinventé par Artotop, tissus français transformés, première moitié du XIXe siècle, art classique avec une touche moderne réinventé par Artotop

RF3B08ERT–Une composition abstraite vibrante avec des traits audacieux de violet, vert et des notes de jaune, suggérant un thème floral avec un mouvement dynamique et une texture., Un motif circulaire vibrant avec un feuillage vert luxuriant entrelacé avec des motifs floraux audacieux et colorés, créant un mélange artistique de nature et de design abstrait. Art classique avec une touche moderne réinventé par Artotop, tissus français transformés, première moitié du XIXe siècle, art classique avec une touche moderne réinventé par Artotop

RF3B08415–Un fond texturé rempli de lignes entrelacées et de formes douces et colorées qui créent un effet abstrait rêveur, suggérant un thème naturel ou floral., Un design circulaire avec des motifs floraux complexes entrecoupés de sections texturées ressemblant à de l'herbe. Les fleurs sont vibrantes, ajoutant un contraste frappant à la disposition globale. Art classique avec une touche moderne réinventé par Artotop, tissus français transformés, première moitié du XIXe siècle, art classique avec une touche moderne réinventé par Artotop

RF3B091T9–Une composition douce et abstraite avec de doux tourbillons de vert et des notes de rouge et de violet, suggérant un thème naturel et floral. Les couleurs se mélangent harmonieusement, créant une atmosphère de rêve., Une surface douce et vert pastel présente des roses rouges délicates et délavées entrelacées avec des feuilles vertes douces, créant un motif serein et floral. Art classique avec une touche moderne réinventé par Artotop, tissus français transformés, première moitié du XIXe siècle, art classique avec une touche moderne réinventé par Artotop

RF3B0C1HR–Une composition abstraite avec un mélange dynamique de couleurs et de formes, créant un sentiment de mouvement et d'énergie. L'arrangement suggère un thème floral, avec des verts vifs, des rouges et des notes de bleu se mêlant dans un fond plus clair, évoquant une atmosphère vibrante et vivante., Un design circulaire mettant en vedette une variété de motifs floraux et abstraits dans des couleurs vibrantes, entouré d'un fond clair. La composition présente un mélange de tons terreux et de teintes vives, créant un visuel harmonieux et vivant. Art classique avec une touche moderne réinventé par Artotop, tissus français transformés, première moitié

RM3A6ATJT–Un motif circulaire avec un design complexe de fleurs et de formes abstraites, mélangeant des tons gris avec des reflets jaunes vibrants et des notes de vert. La composition globale évoque une touche moderne et artistique tout en mettant en valeur un thème floral. Art classique avec une touche moderne réinventé par Artotop, transformé les tissus français, première moitié du XIXe siècle

RF3B0DM7X–Une vue rapprochée du tissu texturé avec des lignes abstraites en vert vif et orange sur un fond sombre, créant un contraste intrigant., Une surface texturée avec un fond sombre orné de fleurs de tulipe rouge vif et de feuilles vertes délicates. Le design met en valeur un thème naturel et floral avec un élégant mélange de couleurs et de formes. Art classique avec une touche moderne réinventé par Artotop, tissus français transformés, première moitié du XIXe siècle, art classique avec une touche moderne réinventé par Artotop

RF3B0A1DP–Une composition abstraite vibrante avec des motifs tourbillonnants dans des tons de gris, accentués par des touches audacieuses de jaune et des notes d'orange. Le design tisse des formes florales et organiques, créant une expérience visuelle dynamique., Un motif circulaire avec un design complexe de fleurs et de formes abstraites, mélangeant des tons gris avec des reflets jaunes vibrants et des notes de vert. La composition globale évoque une touche moderne et artistique tout en mettant en valeur un thème floral. Art classique avec une touche moderne réinventé par Artotop, tissus français transformés, première moitié du XIXe siècle, art classique

RF3B02461–Un cadre décoratif entoure une note manuscrite, avec des motifs floraux luxuriants dans des couleurs douces, complété par une petite œuvre d'art circulaire qui s'harmonise avec le thème de la nature., art classique avec une touche moderne réinventée par Artotop

RM3A6BE71–Un design circulaire vibrant avec des motifs complexes dans des tons chauds, accentués de motifs floraux et d'éléments décoratifs qui suggèrent un thème vivant et festif. Art classique avec une touche moderne réinventé par Artotop, transformé les tissus français, première moitié du XIXe siècle

RF3B0C57F–Une vue rapprochée présentant un motif de tissu vert éclatant orné de feuilles complexes et de motifs floraux, mettant en évidence un thème botanique luxuriant., Un tissu vert éclatant orné de motifs floraux complexes, avec des grappes de feuilles et de fleurs entrecoupées de détails fins en pointillés. Art classique avec une touche moderne réinventé par Artotop, tissus français transformés, première moitié du XIXe siècle, art classique avec une touche moderne réinventé par Artotop
![Une couverture complexe avec une typographie ornée, ornée d'éléments floraux décoratifs et d'illustrations d'animaux, mettant l'accent sur un thème historique. Le titre suggère un lien avec l'histoire naturelle, et l'esthétique générale évoque un sens du charme vintage et de l'art., page de titre sur 'illustrations de l'histoire naturelle', différentes espèces, page de titre, Heinrich Rudolf Schinz : Abbildungen aus der Naturgeschichte. Zürich : BEI Friedrich Schulthess, [1824], Art classique avec une touche moderne réinventé par Artotop Banque D'Images Une couverture complexe avec une typographie ornée, ornée d'éléments floraux décoratifs et d'illustrations d'animaux, mettant l'accent sur un thème historique. Le titre suggère un lien avec l'histoire naturelle, et l'esthétique générale évoque un sens du charme vintage et de l'art., page de titre sur 'illustrations de l'histoire naturelle', différentes espèces, page de titre, Heinrich Rudolf Schinz : Abbildungen aus der Naturgeschichte. Zürich : BEI Friedrich Schulthess, [1824], Art classique avec une touche moderne réinventé par Artotop Banque D'Images](https://c8.alamy.com/compfr/3ay4x5n/une-couverture-complexe-avec-une-typographie-ornee-ornee-d-elements-floraux-decoratifs-et-d-illustrations-d-animaux-mettant-l-accent-sur-un-theme-historique-le-titre-suggere-un-lien-avec-l-histoire-naturelle-et-l-esthetique-generale-evoque-un-sens-du-charme-vintage-et-de-l-art-page-de-titre-sur-illustrations-de-l-histoire-naturelle-differentes-especes-page-de-titre-heinrich-rudolf-schinz-abbildungen-aus-der-naturgeschichte-zurich-bei-friedrich-schulthess-1824-art-classique-avec-une-touche-moderne-reinvente-par-artotop-3ay4x5n.jpg)
RF3AY4X5N–Une couverture complexe avec une typographie ornée, ornée d'éléments floraux décoratifs et d'illustrations d'animaux, mettant l'accent sur un thème historique. Le titre suggère un lien avec l'histoire naturelle, et l'esthétique générale évoque un sens du charme vintage et de l'art., page de titre sur 'illustrations de l'histoire naturelle', différentes espèces, page de titre, Heinrich Rudolf Schinz : Abbildungen aus der Naturgeschichte. Zürich : BEI Friedrich Schulthess, [1824], Art classique avec une touche moderne réinventé par Artotop

RF3B0DNCR–Un arrangement abstrait de feuilles vibrantes et de formes circulaires, créant un jeu dynamique de couleurs sur un fond sombre. La composition suggère un thème naturel, avec des notes d'éléments floraux et de formes organiques., Une assiette ronde et décorative ornée d'un motif floral vibrant avec des grappes de baies rouges et de feuilles vertes sur un fond sombre. Art classique avec une touche moderne réinventé par Artotop, tissus français transformés, première moitié du XIXe siècle, art classique avec une touche moderne réinventé par Artotop

RF3AYN3MP–Un design complexe mettant en vedette deux êtres mythiques flanquant un vase central. Des motifs tourbillonnants élaborés et des motifs floraux créent un sentiment d'harmonie et de mouvement, soulignant le thème fantastique. La composition générale évoque un riche récit artistique. Ornement avec deux Tritons, de quatre vignettes, c. 1544, Sebald Beham, allemand, 1500-1550, Allemagne, gravure en noir sur papier ivoire, 22 x 54 mm (image/feuille, rognée à la plaque) Art classique avec une touche moderne réinventée par Artotop

RF3B0CTPR–Une composition abstraite avec un mélange de teintes bleues douces et de formes organiques, évoquant un sentiment de tranquillité et de fluidité. Le design suggère un thème floral ou naturel, avec des motifs qui rayonnent vers l'extérieur, créant une atmosphère rêveuse et éthérée., Un design circulaire avec des motifs floraux délicats dans différentes nuances de bleu, créant une esthétique douce et tranquille. Art classique avec une touche moderne réinventé par Artotop, tissus français transformés, première moitié du XIXe siècle, art classique avec une touche moderne réinventé par Artotop

RF3B0CJP9–Une composition douce et abstraite aux formes douces qui suggèrent un thème floral ou organique, avec des tons doux qui créent une atmosphère tranquille. Le design combine des lignes fluides et des formes circulaires, évoquant un sentiment de calme et d'harmonie., Un motif délicat de cercles doux et superposés et de formes florales, évoquant un sentiment de tranquillité et d'harmonie. Le design présente un flux doux, rappelant les fleurs ou les orbes suspendus, créant une ambiance éthérée. Art classique avec une touche moderne réinventé par Artotop, tissus français transformés, première moitié du XIXe siècle, art classique avec un

RF3AY4M9K–Affiche théâtrale ornée de motifs floraux élaborés entourant le titre « Theâtre en Martyrs » et « Schau-Bühne der Martyrer », ainsi que des illustrations complexes qui reflètent un thème historique ou artistique. La conception se caractérise par un artisanat détaillé, évoquant un sens du drame et de l'art., Title page to 'Show-stage of the Martyrs', Picutra with martyrs and inscriptio 'per angusta ad augustam', Copperplate gravure, title page, Luyken, Jan (inv. Et fec.), Jan Luyken : Théâtre des martyrs : la mort de J.Christ jusqu'à present : depuis très belles tailles-douces

RM3A6BDE9–Un arrangement fantaisiste d'éléments floraux entrelacés avec des formes abstraites, mettant en valeur un mélange de teintes douces et de détails complexes. Le design respire une élégance ludique, parfait pour un thème inspiré de la nature. Art classique avec une touche moderne réinventé par Artotop, transformé les tissus français, première moitié du XIXe siècle

RF3B0AYX4–Un motif complexe avec différentes nuances de motifs floraux verts et de feuilles, conçu dans un arrangement délicat et détaillé., Un motif circulaire avec un motif complexe de vignes feuillues et de fleurs stylisées dans des tons de vert, créant un thème botanique vibrant et harmonieux. Art classique avec une touche moderne réinventé par Artotop, tissus français transformés, première moitié du XIXe siècle, art classique avec une touche moderne réinventé par Artotop

RF3B09JGT–Un groupe de raisins est représenté avec des feuilles vertes vibrantes, entourées de points délicats, capturant un thème botanique., Un design circulaire avec un grand motif de fleurs dans les tons de vert, entouré de vignes délicates et de points, créant un motif floral complexe. L'effet global est fantaisiste et vintage-inspiré. Art classique avec une touche moderne réinventé par Artotop, tissus français transformés, première moitié du XIXe siècle, art classique avec une touche moderne réinventé par Artotop

RF3B0DBWJ–Une vue rapprochée de formes sombres et vertes abstraites, se mélangeant pour créer une sensation de mouvement et de profondeur. L'interaction des couleurs suggère un thème naturel, rappelant le feuillage ou les formes organiques., Un motif rond avec un fond sombre orné de motifs floraux verts luxuriants et de feuilles délicates. Art classique avec une touche moderne réinventé par Artotop, tissus français transformés, première moitié du XIXe siècle, art classique avec une touche moderne réinventé par Artotop

RF3B0B812–Une composition abstraite avec des formes douces et organiques dans une teinte chaude et pâle, créant une sensation de légèreté et de mouvement doux., Un arrangement fantaisiste d'éléments floraux entrelacés avec des formes abstraites, mettant en valeur un mélange de teintes douces et de détails complexes. Le design respire une élégance ludique, parfait pour un thème inspiré de la nature. Art classique avec une touche moderne réinventé par Artotop, tissus français transformés, première moitié du XIXe siècle, art classique avec une touche moderne réinventé par Artotop

RF3B0DN6K–Un arrangement vibrant de formes organiques abstraites et de lignes fluides, infusé d'un mélange de couleurs qui suggèrent un thème botanique vivant. L'interaction des formes crée une composition dynamique et fantaisiste qui rappelle la nature., Une plaque décorative avec un motif floral, avec des couleurs vibrantes et des détails complexes représentant des feuilles et des fleurs sur un fond sombre. Art classique avec une touche moderne réinventé par Artotop, tissus français transformés, première moitié du XIXe siècle, art classique avec une touche moderne réinventé par Artotop

RF3B0CA06–Une composition abstraite avec un mélange de couleurs pastel douces et de silhouettes, créant une atmosphère onirique. Les formes délicates suggèrent un thème naturel, tandis que les éléments sombres contrastés ajoutent de la profondeur et de l'intrigue., Un design doux et circulaire avec des formes florales délicates dans des couleurs discrètes, sur un fond pâle qui crée une atmosphère douce et sereine. Art classique avec une touche moderne réinventé par Artotop, tissus français transformés, première moitié du XIXe siècle, art classique avec une touche moderne réinventé par Artotop

RF3AYNDYC–Un personnage s'agenouille tout en se concentrant intentionnellement sur une œuvre d'art, tenant un pinceau dans une main et examinant un motif coloré et à motifs dans l'autre. La tenue présente des motifs floraux vibrants, suggérant un thème culturel ou artistique. Boy as Hotei, d'une série sans titre d'enfants comme les sept dieux de la bonne fortune, années 1780, Kitao Shigemasa, japonais, 1739-1820, Japon, impression sur bois couleur, oban, 15 1/8 × 10 po. Art classique avec une touche moderne réinventé par Artotop

RF3B08F5P–Une composition minimaliste avec des formes douces et abstraites dans des couleurs discrètes qui évoquent un sentiment de calme et de simplicité. Les courbes douces et les formes organiques suggèrent un thème naturel, invitant à la réflexion et à la sérénité., Un design circulaire avec des éléments floraux délicats dans des couleurs douces, avec des feuilles et des fleurs minutieusement détaillées positionnées sur les bords, créant une composition harmonieuse et équilibrée. Art classique avec une touche moderne réinventé par Artotop, tissus français transformés, première moitié du XIXe siècle, art classique avec une touche moderne réinventé par Artotop

RF3B0B981–Une composition vibrante et abstraite avec un mélange de teintes chaudes, de motifs complexes et de formes ludiques qui créent une sensation de mouvement et d'énergie. Le design met en valeur une juxtaposition d'éléments floraux et géométriques, invitant à l'exploration et à l'imagination., Un design circulaire vibrant avec des motifs complexes aux teintes chaudes, accentués de motifs floraux et d'éléments décoratifs qui suggèrent un thème vivant et festif. Art classique avec une touche moderne réinventé par Artotop, tissus français transformés, première moitié du XIXe siècle, art classique avec une touche moderne réinventé par Artotop
RM3A6C6R3–Une composition circulaire et abstraite avec des motifs doux et tourbillonnants et des teintes discrètes, évoquant un sens des formes organiques et des motifs inspirés de la nature. Les feuilles vertes délicates et les centres sombres suggèrent un thème floral ou botanique, créant une expérience visuelle tranquille et harmonieuse. Art classique avec une touche moderne réinventé par Artotop, transformé les tissus français, première moitié du XIXe siècle

RF3B05GKE–Son design complexe est orné d'éléments violets audacieux et jaunes vifs pour un contraste saisissant. Les motifs comprennent des formes organiques et des accents en pointillés, suggérant un thème floral ou abstrait., Un design circulaire avec des motifs complexes de feuilles et de fleurs dans des teintes violettes et vertes vibrantes, créant un motif visuellement frappant et artistique. Art classique avec une touche moderne réinventé par Artotop, ornement grec transformé et ornement étrusque, art classique avec une touche moderne réinventé par Artotop

RF3B08C24–Un motif textile vibrant avec des fleurs et des feuilles stylisées, entrecoupées de gouttes de pluie abstraites, le tout rendu dans des tons de bleu et de crème. Le design met en valeur des détails complexes et un thème ludique inspiré de la nature., Un tissu bleu éclatant avec des motifs floraux et de feuilles complexes, accentués par des touches d'orange, créant un design frappant qui ajoute de la profondeur et du caractère. Art classique avec une touche moderne réinventé par Artotop, tissus français transformés, première moitié du XIXe siècle, art classique avec une touche moderne réinventé par Artotop

RF3B0CX9T–Une série de formes abstraites et organiques de différentes tailles, créant un motif ludique qui évoque une sensation de mouvement et de fluidité. Les dessins s'entrelacent dans un mélange harmonieux, suggérant un thème fantaisiste, inspiré de la nature., Une surface circulaire ornée d'un motif fantaisiste de petites formes florales interconnectées dans des tons violets, sur un fond clair. Art classique avec une touche moderne réinventé par Artotop, tissus français transformés, première moitié du XIXe siècle, art classique avec une touche moderne réinventé par Artotop

RF3B0AE8F–Un design vibrant et abstrait avec des formes organiques et des motifs complexes dans différentes nuances de vert, accentués par des points et des lignes colorés qui suggèrent un thème ludique et inspiré de la nature., Un tissu vert vibrant présente un motif complexe avec des formes florales et abstraites stylisées, accentuées de touches de brun, bleu et noir. Le design crée une esthétique vivante et ludique, parfaite pour le textile ou la mode. Art classique avec une touche moderne réinventé par Artotop, tissus français transformés, première moitié du XIXe siècle, art classique avec une touche moderne réinventé par Artotop

RF3B0D71P–Un motif vibrant présente des formes répétitives ressemblant à des étoiles, intercalées sur un fond de lignes verticales, créant une sensation de mouvement dynamique et d'énergie. Les couleurs évoquent un thème aquatique serein, améliorant le design fantaisiste., Un motif circulaire avec des motifs complexes et répétés ressemblant à des fleurs sur un fond bleu doux, créant un design visuellement attrayant. Art classique avec une touche moderne réinventé par Artotop, tissus français transformés, première moitié du XIXe siècle, art classique avec une touche moderne réinventé par Artotop

RF3B0CGXT–Un motif avec des formes stylisées de feuilles, disposées symétriquement et dans une teinte douce et discrète, créant une sensation de légèreté et de texture. Le design évoque un thème botanique, offrant une sensation tranquille et organique., Un motif circulaire avec des motifs floraux délicats et stylisés disposés dans un motif répétitif, créant une esthétique harmonieuse et élégante. Le ton général est léger et aéré, suggérant une atmosphère fraîche et accueillante. Art classique avec une touche moderne réinventé par Artotop, tissus français transformés, première moitié du XIXe siècle, art classique avec une touche moderne réinventé par

RF3B08960–Un design vibrant avec des feuilles tourbillonnantes et des formes douces et arrondies, en interaction avec les tons chauds et les contrastes subtils. Les formes organiques créent un sentiment de mouvement et de profondeur, évoquant un thème botanique., Un design circulaire avec un motif floral avec des feuilles et des fleurs dans des tons doux, sur un fond doux. L'arrangement évoque une esthétique vintage, mettant en valeur les détails complexes du feuillage. Art classique avec une touche moderne réinventé par Artotop, tissus français transformés, première moitié du XIXe siècle, art classique avec une touche moderne réinventé par Artotop

RF3B0CD3D–Une représentation abstraite avec des formes douces et fluides dans un mélange harmonieux de jaune et de vert, évoquant un sentiment de calme et de tranquillité. Des notes subtiles de tons plus sombres créent de la profondeur et de l'intrigue, invitant à un regard de plus près., Une composition circulaire et abstraite avec des motifs doux et tourbillonnants et des teintes discrètes, évoquant un sentiment de formes organiques et de motifs inspirés de la nature. Les feuilles vertes délicates et les centres sombres suggèrent un thème floral ou botanique, créant une expérience visuelle tranquille et harmonieuse. Art classique avec une touche de modernité réinventé par Artotop, a transformé les tissus français, première moitié de la

RF3AYNCHD–Une femme vêtue d'une tenue d'époque, assise à un petit piano, apparaît absorbée par sa musique alors qu'elle tourne les pages d'un drap avec un ornement floral accentuant sa coiffure. La scène évoque un sentiment de nostalgie, soulignant le thème des mélodies oubliées. Here’s Songs of Love and Maids Forsaken, publié le 30 mars 1793, James Gillray (anglais, 1756-1815), Edité par Hannah Humphrey (anglais, c. 1745-1818), Angleterre, gravure en brun foncé, avec coloration manuelle, sur papier tissé crème, 207 × 188 mm (image), 250 × 224 mm (plaque/feuille) Art classique avec une touche moderne réinventé par Artotop